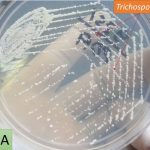
Trichosporon on PDA

Collection Group: Mycology
Trichosporon: Introduction, Colony Characteristics, Pathogenecity, Lab Diagnosis and Treatment
Introduction of Trichosporon The fungus, Trichosporon, genus is characterized by...
Introduction of Trichosporon The fungus, Trichosporon, genus is characterized by...
Trichosporon LPCB Preparation: Introduction, Pathogenecity, Lab Diagnosis and Treatment
 Trichosporon LPCB preparation Trichosporon LPCB preparation as shown above image has hyaline,...
Trichosporon LPCB preparation Trichosporon LPCB preparation as shown above image has hyaline,...
Penicillium marneffei in KOH Mount of Sputum: Introduction, Clinical Features and Lab Diagnosis
 Penicillium marneffei in KOH Mount of Sputum Penicillium marneffei in...
Penicillium marneffei in KOH Mount of Sputum Penicillium marneffei in...
